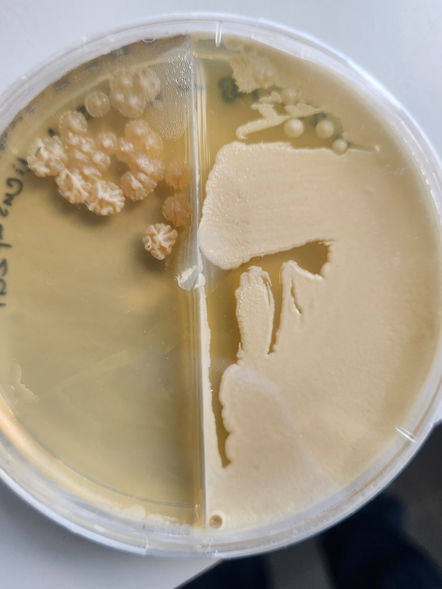

Interdisciplinary microbiome research has become the forefront of society's pressing issues and solutions.
And we're currently thriving in a period of its factorial growth📈
I'm Shabana Hoosein, a soil microbiome researcher and data scientist, specializing in bioinformatics, machine learning, and Python/R programming.
I'm also well-versed in metagenomics, transcriptomics, and metabolomics,
using both computational and wet-lab techniques
( ie. infinite scripting, database building, mass spectrometry, and LCMS)
to answer fundamental and applied research questions
about microbial coexistence, turnover, synthetic communities
and microbiome manipulations.
To learn more or connect on an opportunity, please feel free to reach out. | Scroll down to find ways to get in touch.
Microbes are the silent warriors; these tiniest beings possess the strength to spark a revolution that can have monumental impacts in the world of science.
-Aloo Denish Obiero
Just scroll on through
Scenes from Current Projects